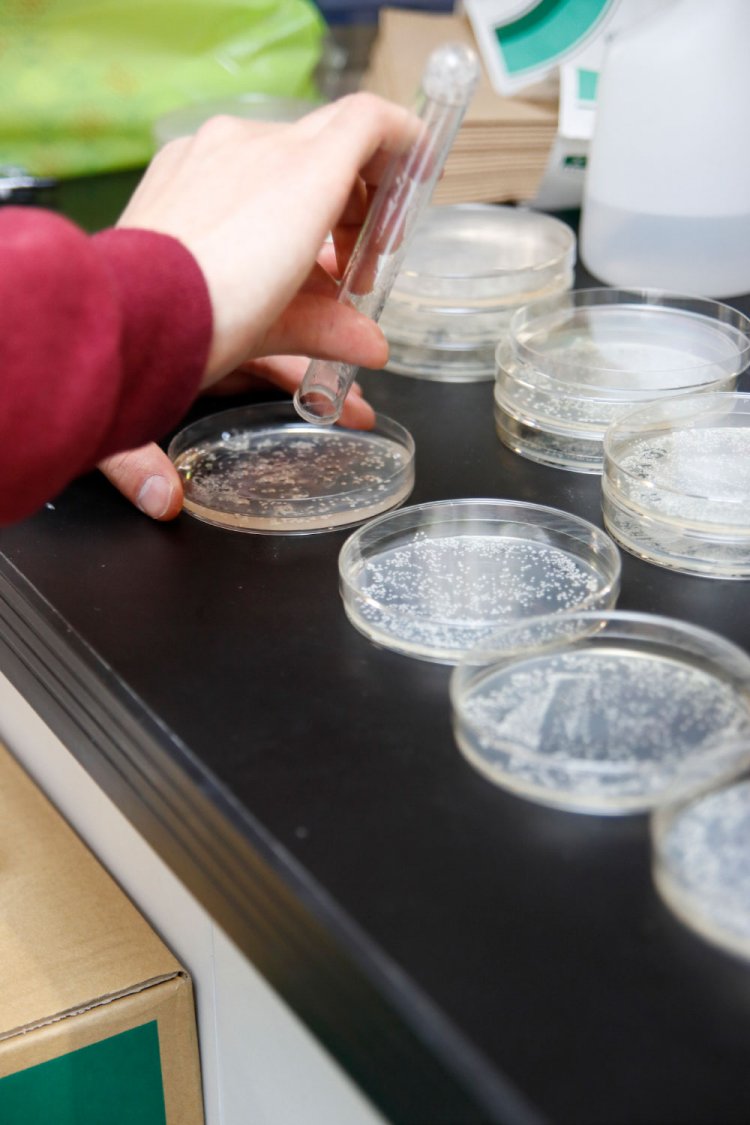
微生物が相手の研究が日々行われる。

お話を聞いたのは
未成年でもお酒をしっかり学びます
東京農業大学にはこんな名前の学科がある。 「応用生物科学部醸造科学科」 。その名前から既に迫力があるが、この学科はお酒はもちろん、微生物、チーズ、パン、キノコ、醤油や味噌、さらには環境問題とあらゆる研究のプロフェッショナルが一堂に会する場所だ。 「醸造」 を究めんとする先生がここまでオールジャンルで揃う大学はほかにはないという。今回はその全貌に迫っていきたい。
「醸造科学科の学生は、1年生では研究の基礎となる化学や実験技術を学び、2年生になってから少しずつ専門的な分野の勉強をしていきます。醸造は化学がないと成り立たない学問なんです」。そう教えてくれたのは微生物工学研究室の數岡(かずおか)孝幸先生だ。学生は3年生から専門的な研究や実験を行い、実際に味噌や醤油を作ることもあるという。
「ほとんどの学生が20歳を迎える3年生の後半には酒類生産学実験も行われます」と數岡先生。ここまで話を伺って衝撃が走る。そう、忘れていたが、大学入学時は多くの学生が10代だ。未成年が醸造やお酒について学んでいるということ自体がかなりスゴい。
「未成年に対しお酒のことを教えるという難しさも感じますね(笑)。1年生のときはアルコールが身体に及ぼす影響などを学びます。3年生で初めてさまざまなお酒を作り、利き酒も行います」 。
大学の授業でお酒を作り、利き酒までやるとはさすが醸造科学科だ。そして3年生の後半にはビッグイベントが待っている。研究室の決定だ。6つの研究室から自分が入る研究室を決め、4年生は卒業研究に没頭。学生それぞれが専門的に研究を行うのだ。
ここで改めて伺いたいのは、數岡先生の研究テーマ。先生が在籍しているのは微生物工学研究室だが、一体どんな研究をされているのだろう。
「私は酵母の研究をしています。酵母が変わるとお酒の風味も変わってくる。今は協会酵母を使っている酒蔵が大半なのですが、これ以外の酵母をもっと増やそうというのが目標です」 。日本酒好きの人はご存じかもしれないが、日本醸造協会が頒布している 「協会酵母」というものがある。ベースとなっているものが6種類あり、分類しても20種程度しかない。いつも口にしているお酒のほとんどが協会酵母で作られているというわけだ。數岡先生の研究は、これとは別に新たな酵母を作るというもの。つまり、新しい味や風味の日本酒を造ることにつながる、とんでもない研究なのだ。
「私が関わった酵母だけで、年間100万ℓくらい作られているんです。OBの蔵と東京農大花酵母研究会というのを作っていまして、花から作る花酵母を使った日本酒を広めていきたいと頑張っていますよ」 。それはスゴい! 新たな味を生み出す研究をしているとは、日本酒ファンからするとまさに神様のような人じゃないですか。
一方で數岡先生のように実際に日本酒に関わることになる卒業生は一握りなのだという。食品関係の会社に就職する学生の割合が高いのがこの学科の特徴だが、それまで培った研究とは直接関係のない企業に就職する人も多い。「大学の授業や研究を通して得られるものとして一番大きいのはコミュニケーションの力だと思っています。狭い部屋にたくさんの人が集って研究をするので人との距離感を学べるはず。小さなコミュニティの中でチームでうまくやっていくということを、どの研究室でもしっかり経験できると思います」 。なるほど、研究というと数字とにらめっこしたり、分析作業をドライにこなすイメージだったが、醸造科学科では人と人との関わり方もじわじわと醸造されているのだ。
一度は立ち寄りたい心躍る農大スポット
研究室に足を踏み入れることはできないが、一度は行っておきたい農大スポットがある。世田谷キャンパスから歩いてすぐのところにある 『 「食と農」の博物館』 。こちらは東京農業大学名誉教授で醸造科学科の生みの親である住江金之 (すみのえきんし) に関する資料や酒器コレクションが並び見ごたえ十分。動植物のコレクションを公開しているバイオリウムもあり、ゆったり楽しめる博物館だ。 写真の美しい日本酒ディスプレイは必見。こちらでは卒業生の蔵元を紹介している。280本もの酒瓶が並ぶさまに圧倒されてほしい。
いやいや、酒は見るものではない飲むものだという、敬虔(けいけん)な日本酒狂にオススメなのが 『 「農」 の蔵』 だ。世田谷代田駅にあるこちらのお店では、醸造科学科OBが手がけたお酒を常備。普通はめぐり会えないような珍しい日本酒も普通に売っていて驚くはずだ。日本酒を買う穴場として既に知っている人は知っているスポット。日本酒好きならチェックしておかないと!
醸造を志し、日々難しい研究に励む東京農業大学醸造科学科。日本酒ファンは絶対に何らかの形でお世話になっているはずだし、これからも必ずお世話になり続けるはず。今宵は一杯やりながら、どうか彼らの飽くなき探求心に思いをはせてみてほしい。
『「食と農」の博物館』詳細
『農大ショップ 「農」の蔵』詳細
応用生物科学部醸造科学科にはこんな研究室があるぞ!
醸造微生物学研究室
酵母の研究を行う。生理・生態・遺伝子解析といった視点から酵母を分類学的に解析。酒の風味を作り出す遺伝子なども研究。日本酒をはじめあらゆる酒文化の発展に貢献している。
酒類生産科学研究室
お酒造りそのものを考える研究室。清酒生産関連に加え麹菌などまだ明らかになっていないものを遺伝子・酵素レベルから分析、各種化合物の生成メカニズムなどの研究にも取り組む。
微生物工学研究室
人のために役立つ技術「工学」を研究する研究室。清酒酵母を実用化するまでのステップを改良するなど、実用化に焦点を当てた研究を行っている。酒以外にキノコも研究対象。
調味食品科学研究室
味噌、醤油をはじめ新しい調味料も開発している。「塩麹」を世に広めた前橋健二教授が在籍するのもこちら。食品のおいしさは元より安心や安全を目指す道を追究している。
発酵食品化学研究室
酢酸菌や乳酸菌を作る微生物が対象。今まで研究が詳しくされていなかったという、くさやの研究もスタートしている。ほかにもチーズ、発酵食品など幅広く研究している。
醸造環境科学研究室
醸造や食品工業などから排出される、環境の中の微生物を研究する。排水や水質調査といった環境に関わること全般を対象とし、ウイルスの生態系などの研究も行っている。
取材・文=半澤則吉 撮影=原幹和
『散歩の達人』2022年2月号より